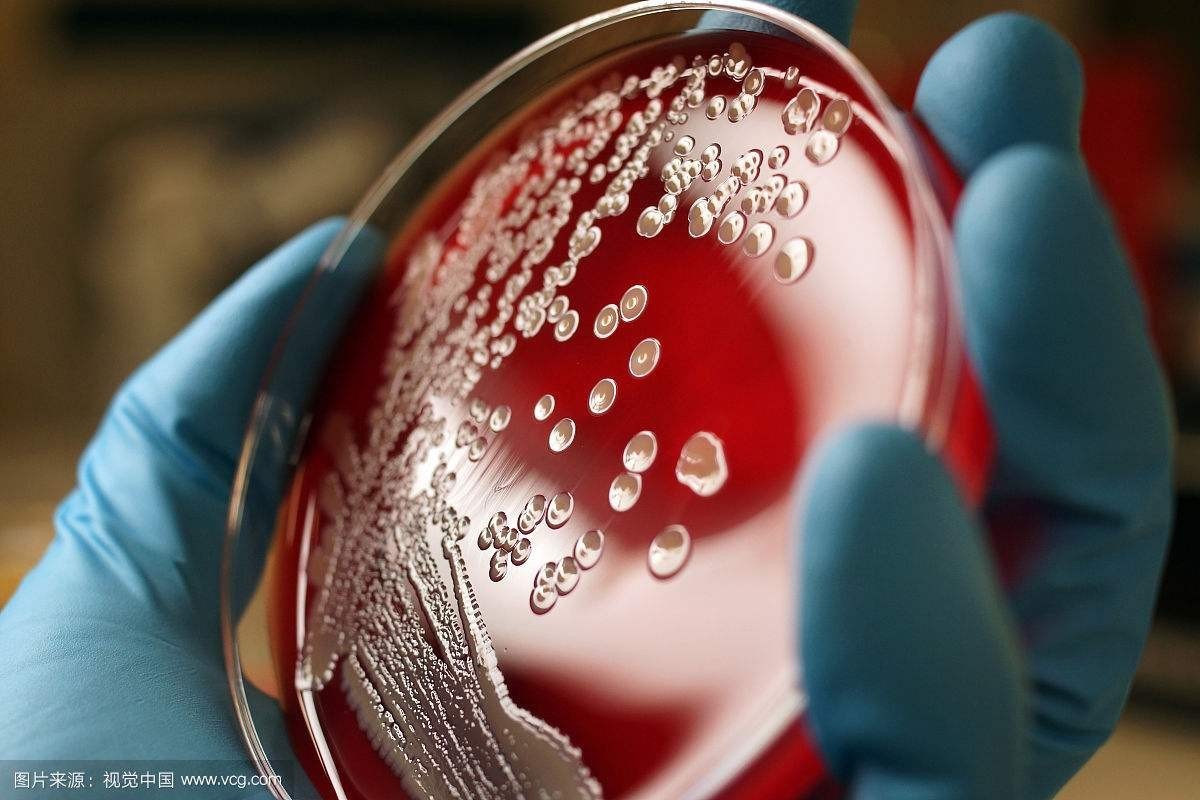
女生看过来!穿高跟鞋磨破脚后跟 女子竟中毒晕

【图】穿高跟鞋磨破皮怎么办 4个技巧让你成为
500x400 - 40KB - JPEG

唐嫣穿高跟鞋磨破脚踝 裸色创可贴遮盖现场化
640x429 - 64KB - JPEG
【图】每次穿高跟鞋脚后跟都会被磨破,太疼了
800x600 - 32KB - JPEG

女生看过来!穿高跟鞋磨破脚后跟 女子竟中毒晕
1024x633 - 133KB - JPEG
女生看过来!穿高跟鞋磨破脚后跟 女子竟中毒晕
1200x800 - 129KB - JPEG

女生看过来!穿高跟鞋磨破脚后跟 女子竟中毒晕
640x416 - 38KB - JPEG
Ella为穿高跟鞋脚后跟磨破,搞怪发文:真怀念当
750x1070 - 82KB - JPEG

第二件半价 compeed 护脚膏 只要在穿高跟鞋或
800x1067 - 73KB - JPEG

唐嫣穿高跟鞋磨破脚踝
494x408 - 115KB - JPEG

Ella为穿高跟鞋脚后跟已磨破,搞怪发文:女明星
750x710 - 43KB - JPEG

第二件半价 compeed 护脚膏 只要在穿高跟鞋或
640x640 - 39KB - JPEG

穿高跟鞋好苦恼,每次都磨破脚,谁来给我推荐
320x220 - 15KB - JPEG

为什么你穿婚鞋又是磨破脚又是腿酸?最大bug
498x243 - 29KB - JPEG

穿到脚红肿破皮!空姐想废7公分高跟鞋 华航:可
600x414 - 76KB - JPEG
![佳丽卖力训练 角逐国际旅游小姐[高清大图]](http://res.news.ifeng.com/b52d6dcee929704a/2011/0321/rdn_4d87162c1d4bd.jpg)
佳丽卖力训练 角逐国际旅游小姐[高清大图]
950x600 - 207KB - JPEG
一、脚穿鞋磨破了怎么办?如果只是破皮避免出现伤口感染,平时尽量穿着比较舒适的鞋子,减少与鞋子的摩擦,
展开全部 我穿高跟鞋的时候也被磨破过,不过贴个创可贴就没事了,也不会磨脚,鞋子多穿穿就没事了
脚趾头穿高跟鞋磨破了一大块皮怎么办?可以贴创可贴吗?谢,
穿高跟鞋把脚磨破了怎么办?穿高跟鞋把脚磨破了怎么办。要是化脓了在怎么办。脚要是肿了在怎么办
展开全部 高跟鞋是要穿紧点的才不会磨,现在可以买个后跟帖用。贴在后跟上,鞋子略微有点紧就好啦。展开
穿新鞋子脚趾上面都磨破了,怎么方法三:不是所有的新鞋都一定磨脚,肯定是你买的鞋子样式有问题。